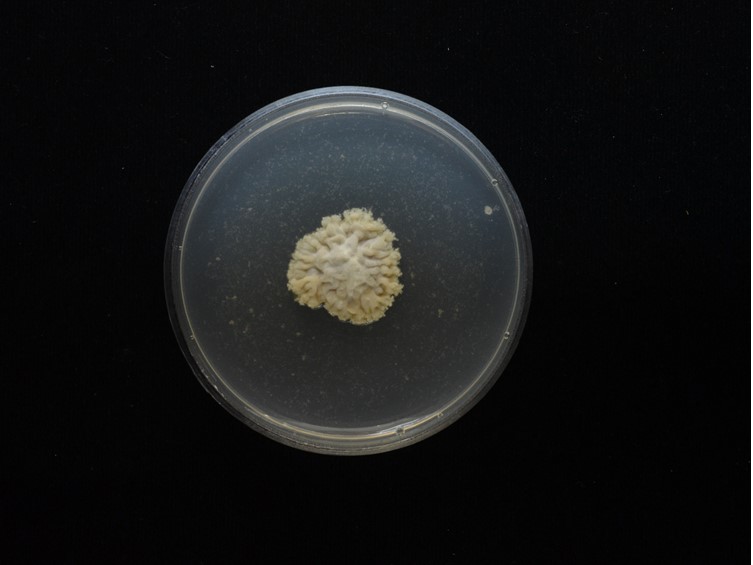

Holotype:
THAILAND, Trat Province, Mu Ko Chang National Park, 8 May 2018, S. Mongkolsamrit, W. Noisripoom, J.J. Luangsa-ard, W. Himaman, P. Jangsantear, B. Sakolrak, holotype BBH 44148, ex-type living culture TBRC 9710.
Habitat:
Buried in the soil.
Host:
Orthoptera nymph.
Description:
 Stroma arising from head of orthopteran nymphs.
Stroma arising from head of orthopteran nymphs.  Fertile head globose, 2-4 × 3 mm, gray orange when fresh, light brown. Stipe light cream, 1-4.5 cm long, 1.5-2 mm in breadth.
Fertile head globose, 2-4 × 3 mm, gray orange when fresh, light brown. Stipe light cream, 1-4.5 cm long, 1.5-2 mm in breadth.  Perithecia obclavate, completely immersed, 520-650 × 150-250 μm.
Perithecia obclavate, completely immersed, 520-650 × 150-250 μm.  Asci hyaline, cylindrical, eight-spored, up to 400 μm long, 5 μm wide.
Asci hyaline, cylindrical, eight-spored, up to 400 μm long, 5 μm wide.  Ascospores hyaline, filiform, multi-septate, breaking into 64 cylindrical part-spores, 5-10 × 1-1.5 μm.
Ascospores hyaline, filiform, multi-septate, breaking into 64 cylindrical part-spores, 5-10 × 1-1.5 μm.
Culture characteristics:
Colony on PDA in 30 d at 25°C approximately 2 cm in diam, white, velvety with irregular edges, colonies reverse uncolored. Mycelium smooth-walled, septate, hyaline. Conidiogenous cells phialidic, swollen at the base or slightly flask-shaped, in whorls of 2–3, 7–20 × 2–3 μm, with distinct phialide necks, 2–8 × 1 μm. Conidia hyaline, smooth, aseptate, distinctly of two types, mostly cylindrical, 5–7 × 1–1.5 μm, fusiform, 3–5 × 1 μm, mostly aggregated in slimy heads at the apex of three phialides. Sparse synnemata with conidiogenous cells producing conidia observed after 45 days, white, on the center of colonies.
Colony on PDA in 30 d at 25°C approximately 2 cm in diam, white, velvety with irregular edges, colonies reverse uncolored. Mycelium smooth-walled, septate, hyaline. Conidiogenous cells phialidic, swollen at the base or slightly flask-shaped, in whorls of 2–3, 7–20 × 2–3 μm, with distinct phialide necks, 2–8 × 1 μm. Conidia hyaline, smooth, aseptate, distinctly of two types, mostly cylindrical, 5–7 × 1–1.5 μm, fusiform, 3–5 × 1 μm, mostly aggregated in slimy heads at the apex of three phialides. Sparse synnemata with conidiogenous cells producing conidia observed after 45 days, white, on the center of colonies.
Reference:
Mongkolsamrit S, Noisripoom W, Arnamnart N, et al. (2019). Resurrection of Paraisaria in the Ophiocordycipitaceae with three new species from Thailand. Mycological Progress 18: 1213–1230.
DOI: https://doi.org/10.1007/s11557-019-01518-xSpecies |
Strain |
Compound |
Pubchem CID |
Biological activity |
Reference |
|---|
|
Strain |
ITS | LSU | RPB1 | TEF1 |
|---|---|---|---|---|
| BBC 88305 | MH754742 | MK332583 | MK214084 | MK214080 |
| TBRC 9710 | MH754743 | MK332582 | MK214085 | MK214081 |